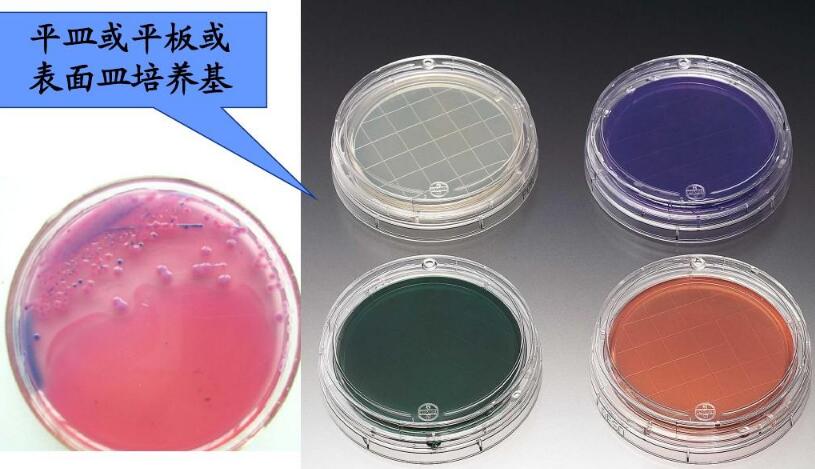
庆大霉素(100IU)和亚碲酸钾(1mg)混合液

万千商家帮你免费找货
0 人在求购买到急需产品
- 详细信息
- 文献和实验
- 技术资料
- 库存:
58
- 供应商:
上海西格
- 规格:
1mL*5支/盒
| 产品名称 | 庆大霉素(100IU)和亚碲酸钾(1mg)混合液 | 货号 | XG-PYJ7011 |
| 英文名称 | 见说明 | 产品规格 | 1mL*5支/盒 |
| 用途 | 仅供科研实验 | 货期 | 现货 |
用法:每支添加于200ml培养基中。
培养基的种类:
1.1 基本培养基和完全培养基
根据其组成,通常分为基本培养基和完全培养基。基本培养基仅含大量元素、微量元素、维生素、氨基酸、糖及水;而完全培养基是在基本培养基的基础上根据不同的培养要求,添加各种植物生长调节物质及附加物。
1.2 固体培养基和液体培养基
在配制培养基时,若加入适量的凝固剂(琼脂)则成为固定培养基;如果不加凝固剂,则为液体培养基。由于固体培养基使用简便,目前使用最为普遍。
1.3 基本培养基的种类及特点
基本培养基的种类非常多,但是较为常用的还是一二十种,如:MS、改良MS、White、改良White、B5、Nitsch、Blaydes、N6、H、VW、改良VW、MT、NT、SH、BL、ER、LS、WS等基本培养基

培养基的使用步骤:
1.琼脂培养基的融化
将培养基放到沸水浴中或采用其他有相同效果的方法(如高压锅中的蒸汽)融化。经过高压灭菌的培养基尽量减少重新加热的时间,避免过度加热。培养基融化后立即移开,室温静置片刻(约2min),以免玻璃容器发生破裂。
融化后的培养基放入47℃~50℃恒温水浴锅中保温,冷却到47℃~50℃所需的时间取决于培养基的类型、体积和在水锅里的分装量。融化后内培养基应尽快使用,放置时间一般不超过4h。剩余的培养基固后不得再次融化使用。特 别是灵敏性培养基,应根据相关标准,缩短融化后放置的时间。
将琼脂培养基倒入类似检测培养使用的独立容器中,插入温度计,记录并保存琼脂的融化温度。
加入样品的培养基应将温度调节到44℃~47℃,或按照相关标准调节温度。
2.培养基的脱气
必要时,在使用前将养基放到沸水浴或蒸汽浴中加热15min,加热时松开容器盖子;加热后盖紧盖子,并迅速冷却至使用温度。
3.添加成分的加入
对热不稳定的添加成分应在培养基冷却至47℃~50℃时加入,灭菌的添加成分加入前应冷却至室温,避免冷的液体会造成琼脂凝胶或形成片状物。将添加成分慢加入培养基并充分混匀,尽快分装到待用的容器中。
4.培养基的弃置
所有污染和未使用的培养基的弃置应采用安全的方式,并符合相关法律法规的规定。
公司正在出售的产品:
Taurolithocholic Acid (sodium salt) STIM2 Antibody MOK (Q286) Antibody (Clone#OTI7F4)
Gap 27 (trifluoroacetate salt) IFNGR2 Antibody STC1 Antibody (Clone#OTI1E9)
LMPTP INHIBITOR 1 hydrochloride JAKMIP3 Antibody MGEA5/OGA Antibody (Clone#20O25)
NAP 226-90 CSPG4 Antibody Cytokeratin 6 Antibody
PPAR agonist 1 NCAM2 Antibody Complement factor B/CFB Antibody (Clone#26C16)
SNX-5422 Mesylate (PF-04929113 (Mesylate)) NDST4 Antibody NAT10 Antibody (Clone#26N34)
GNF362 CRBN Antibody Parvalbumin/PVALB Antibody (Clone#PARV-19)
Raphin1 acetate SLC34A1 Antibody CAMK2A/B/D/G Antibody (Clone#27C04)
XL-888 FOXO1 Antibody EDNRB Antibody (Clone#15C3)
Methyclothiazide NLRX1 Antibody Carboxy peptidase A1/A2/B1 Antibody (Clone#23C13)
Magnolol TAGLN Antibody PHF20L1 Antibody (Clone#OTI6G6)
Tesaglitazar C1orf174 Antibody RCC1 Antibody (Clone#6B11E7)
Milrinone SH2D4A Antibody SNAP Alpha/Beta Antibody (Clone#6B7-3)
GQ-16 MSRB3 Antibody beta-Galactosidase/lacZ (E. coli) Purified Antibody (Clone#BG-02)
Stiripentol RNF215 Antibody Hsp90 alpha/HSP90AA1 Antibody (Clone#OTI3B5)
Tauroursodeoxycholic Acid-d4 MaxSpec? Standard phospho-CDKN1A/P21 (Ser146) Antibody EB2/MAPRE2 Antibody (Clone#OTI7A2)
Phospho-L-Arginine (lithium salt hydrate) SCN2A Antibody CA1 Antibody (Clone#19C89)
庆大霉素(100IU)和亚碲酸钾(1mg)混合液NADH (sodium salt hydrate) TMEM59 Antibody TSHZ1 Antibody (Clone#OTI2G9)
Zilpaterol (hydrochloride) SMYD5 Antibody TrkB/NTRK2 Antibody (Clone#22N08)
风险提示:丁香通仅作为第三方平台,为商家信息发布提供平台空间。用户咨询产品时请注意保护个人信息及财产安全,合理判断,谨慎选购商品,商家和用户对交易行为负责。对于医疗器械类产品,请先查证核实企业经营资质和医疗器械产品注册证情况。
 文献和实验
文献和实验NaHCO3 及15 mmol/L HEPES。低血清培养液是在基础培养液中再加入5μg/ml胰岛素、5ng/ml表皮生长因子、0.3mg/ml谷氨酰胺、100 IU/ml青霉素、100μg/ml链霉素、5×10-7 mol/L氢化可的松以及1.25%胎牛血清。若去掉低血清培养液中的胎牛血清,再加1mg/ml牛血清白蛋白及10μg/ml转铁蛋白,即为无血清培养液; 5. 消化液:0.02%EDTA-0.25%胰蛋白酶溶液,用D-Hanks液配制; 实验方法: 1. 取胚龄
实验材料:1. 人哺乳期早期或断奶后乳汁。2. 培养液:RPMI1640,15%FBS,10%人血清,50μg/ml霍乱毒素,0.5mg/ml氢化可的松,1mg/ml胰岛素。3. HuS(human serum):血库过期的血清,澳大利亚抗原阴性。5cm Nunc塑料培养皿。4. 不含Ca2+ 和Mg2+ 的1×PBS,添加200000IU/L青霉素、200mg/L链霉素和200000U/L庆大霉素,pH7.4。5. 培养用液:1mg/ml胰岛素(Sigma):用6mmol/L盐
实验材料: 1. 早产儿或死亡胎儿的皮肤,也可用手术取下的成体皮肤 2. 1000000U/L中性蛋白酶,0.25%胰蛋白酶 3. MEM和HBSS混合液,添加20mmol/L HEPES、200000IU/L青霉素和200mg/L链霉素和1.5g/L庆大霉素 4. 手术刀、解剖剪、解剖镊、眼科剪,眼科镊 5. 离心管(15ml、50ml) 实验方法: 1. 取厚1.5mm的皮片,用4℃MEM和HBSS混合液冲洗获取的皮肤材料3次。将皮肤置于培养皿中,用镊子
 技术资料
技术资料暂无技术资料 索取技术资料










